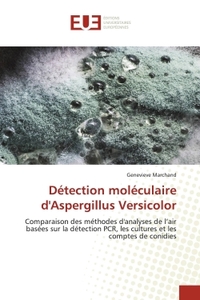
Détection moléculaire d'Aspergillus Versicolor

Nous utilisons des cookies pour améliorer votre expérience. Pour nous conformer à la nouvelle directive sur la vie privée, nous devons demander votre consentement à l’utilisation de ces cookies. En savoir plus.
Chacun son chemin, chacun sa vérité
EAN : 9782414624591
Édition papier
EAN : 9782414624591
Paru le : 5 janv. 2024
16,00 €
15,17 €
Disponible
Pour connaître votre prix et commander, identifiez-vous
Notre engagement qualité
-
Livraison gratuite
en France sans minimum
de commande -
Manquants maintenus
en commande
automatiquement -
Un interlocuteur
unique pour toutes
vos commandes -
Toutes les licences
numériques du marché
au tarif éditeur -
Assistance téléphonique
personalisée sur le
numérique -
Service client
Du Lundi au vendredi
de 9h à 18h
- EAN13 : 9782414624591
- Réf. éditeur : 6915317
- Date Parution : 5 janv. 2024
- Disponibilite : Disponible
- Barème de remise : NS
- Nombre de pages : 158
- Format : H:210 mm L:148 mm E:9 mm
- Poids : 200gr
- Interdit de retour : Retour interdit
- Résumé : L'annonce d'un cancer, les doutes, les peurs, les soins, l'espoir, une vie bouleversée, racontée avec discernement et humour parfois, est la trame de ce récit. Toujours seule à prendre ses décisions, elle énonce : « Je traverse la maladie avec mon corps du mieux que je peux, seule la médecine se bat contre ce cancer incurable. » Dans ce témoignage incisif, elle transmet le courage, l'espoir, la volonté et l'action de vivre. « Il existe en chacun d'entre nous une étincelle d'espoir, une étincelle de vie... une part d'Univers, notre part. Ne te laisse jamais tomber. »
- Biographie : Les sourires et les larmes de Geneviève Marchand ont fait d'elle ce qu'elle est aujourd'hui. Au rythme de ces vies croisées, de ses chagrins et de ses envies... Sa plume, elle, court sur le papier au gré de son humeur. L'écriture reste pour elle avant tout une histoire de coeur...